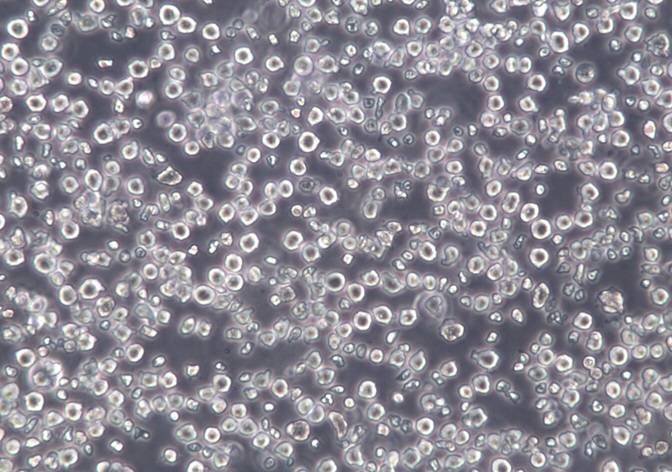

Your present position: Home > 产品中心 147
145-2C11;仓鼠/小鼠杂交瘤细胞
Product Introduction
目录号 |
CC-Y4033 |
细胞英文(简称) |
145-2C11 |
细胞名称 |
145-2C11;仓鼠/小鼠杂交瘤细胞 |
背景资料 |
杂交瘤细胞,用BM10-37小鼠CTL细胞克隆(抗H-2 Kb)免疫美国仓鼠,取脾细胞与Sp2/0-Ag14 骨髓瘤细胞融合得到;抗小鼠CD3,IgG型。 |
细胞来源 |
ATCC |
代次 |
P3 |
规格 |
冻存(1×10^6/管 发2管) 或 复苏(T25一瓶) |
细胞数 |
1x10^6 cells |
价格 |
¥1980 |
生物安全级别 |
1 |
组织来源 |
脾细胞与骨髓瘤细胞融合 |
细胞形态 |
悬浮+贴壁 |
细胞活力 |
95%(Viability by Trypan Blue Exclusion) |
细胞检测 |
细胞不含有HIV-1、HBV、HCV、支原体、细菌、酵母和真菌 |
培养条件 |
IMDM+10% FBS(货号:C2056-1A)+1% P/S |
传代方法 |
首次建议1:2-1:3 两天换液一次 |
冻存条件 |
无血清细胞冻存液(货号:S002) |